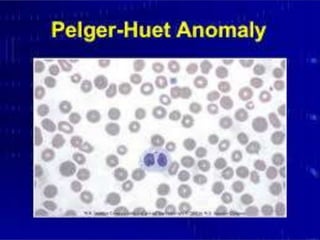
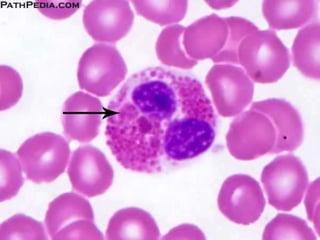
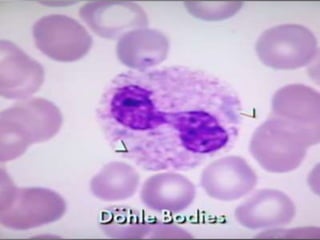
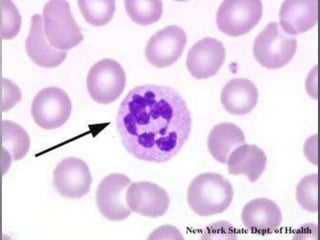

Embed presentation
Downloaded 12 times


















































The document discusses different types of blood disorders including congenital, morphological, qualitative, and quantitative disorders. It also lists different stages of white blood cell development from myeloblast to neutrophil and describes levels of left shift from slight to extreme.